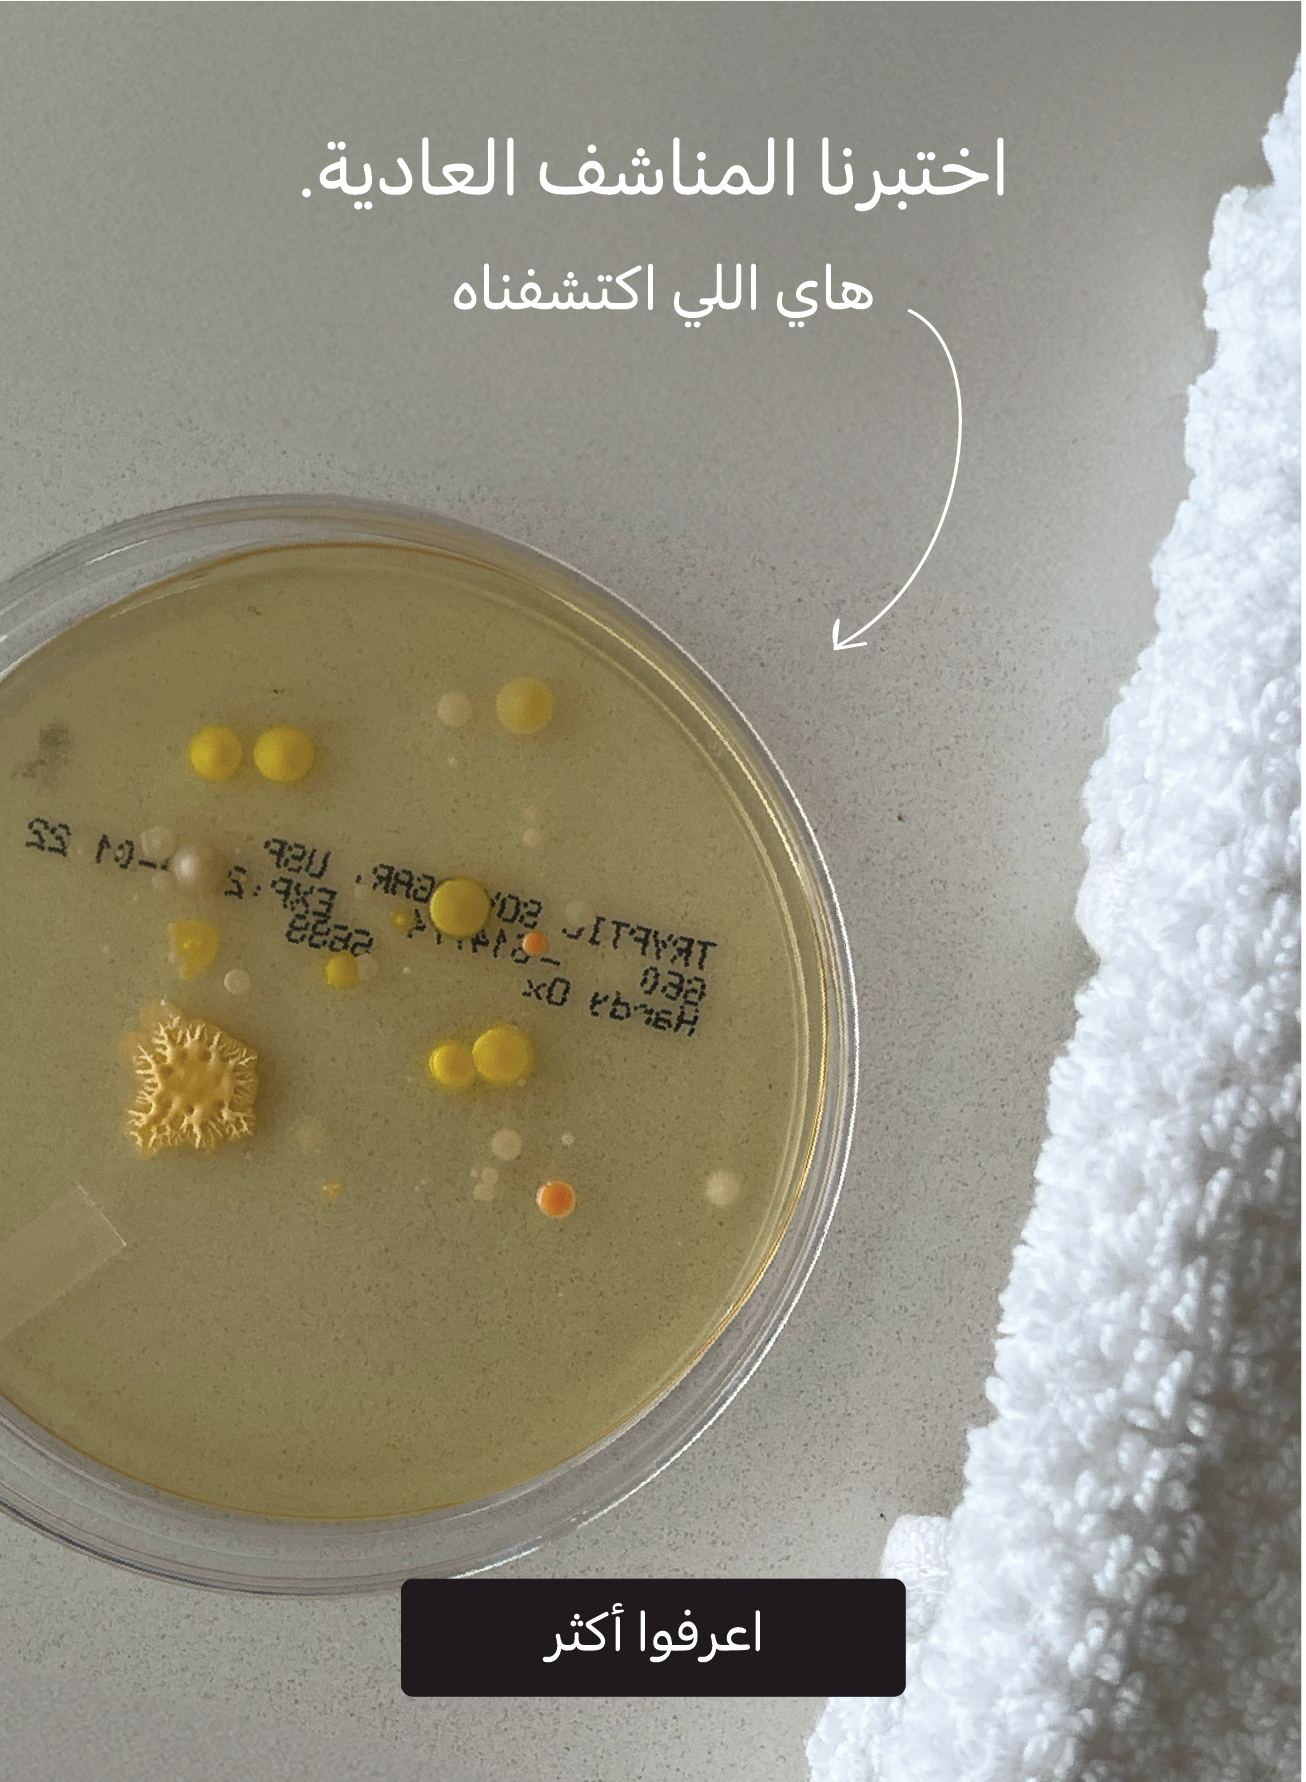

-
باقة الوجهباقة الوجه- Regular price
-
AED 225 - Regular price
-
AED 300 - Sale price
-
AED 225
Add to Cart –25% -
باقة الرياضةباقة الرياضة- Regular price
-
AED 180 - Regular price
-
AED 240 - Sale price
-
AED 180
Add to Cart –25% -
باقة الذهبيةباقة الذهبية- Regular price
-
AED 240 - Regular price
-
AED 320 - Sale price
-
AED 240
Add to Cart –25%


انضموا لرسائلنا، اشتركوا الآن
you get 15% off your first order when you sign up to our newsletter.